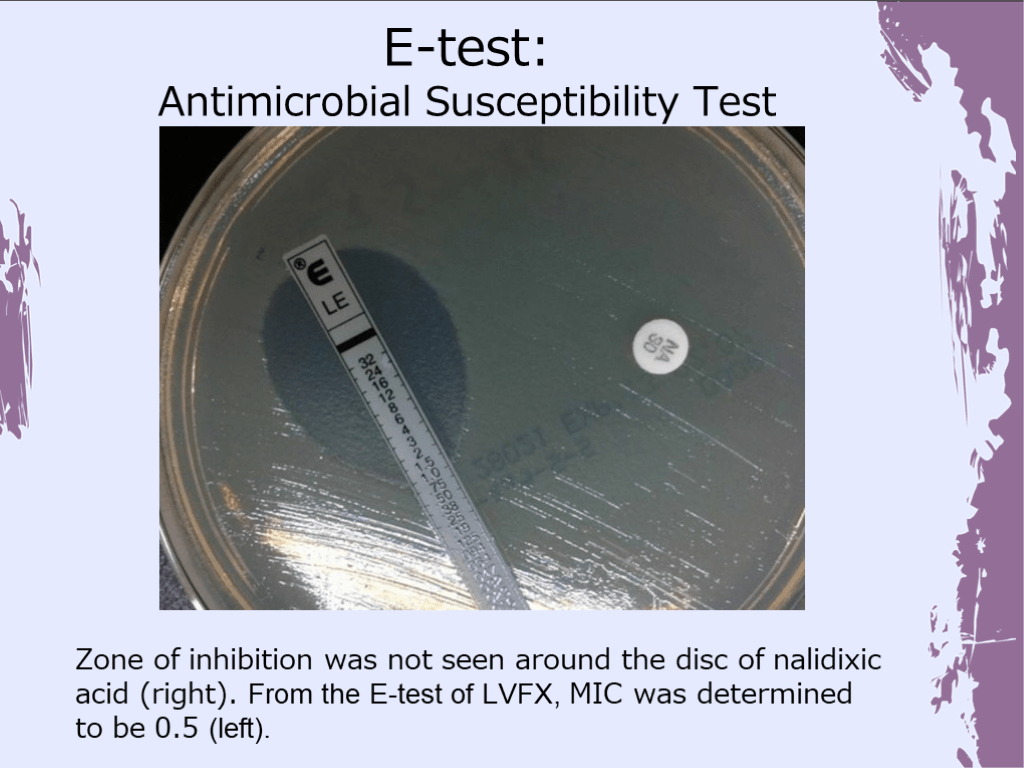

1/44
関連するスライド
「Q&A付き」 " やってみよう!戦略的抗菌薬選択 "
山口裕崇
42609
119
入院患者の発熱の語呂合わせ
関川喜之
18947
145
初期研修医向けグラム陰性桿菌の基本
関川喜之
2790
22
麻疹について最低限・大人のワクチン接種など
野田幸治
17099
66
Principles of Antibiotic Selection: A Case of Recurrent Fever
2,586
5
概要
Principles of Antibiotic Selection: A Case of Recurrent Fever
投稿された先生へ質問や勉強になったポイントをコメントしてみましょう!
0 件のコメント
武藤義和さんの他の投稿スライド
行動経済学で学ぶ 医療現場と感染症 in Antaa X’mas2025
武藤義和
5,351
21
A Case of Fever in the Mertopolitan Area
武藤義和
1,417
3
結核 ~ずっと低蔓延国でいいのに~
武藤義和
41,910
83
このスライドと同じ診療科のスライド
テキスト全文
抗生物質選択の原則と症例報告
#1.
Principles of Antibiotic Selection:A Case of Recurrent Fever Tosei General Hospital Infectious Disease Dept. Dr. Yoshikazu Mutoh
#2.
Case Report: 35yo Man
#3.
Chief Complaints: Fever, vomiting, diarrhea
患者の病歴と身体所見
#4.
49 days prior to admission, the patient complained of a fever, vomiting, and watery diarrhea. He presented to a nearby clinic where he was prescribed LVFX (500mg) PO for 6 days. His condition seemed to improve. The results of the fecal test taken at that time was unremarkable. 6 days prior to admission, he returned to the same clinic with the same complaints of fever with chills, vomiting, and watery diarrhea (twice a day). He was referred to this facility for the purpose of further investigation. Present Medical History
#5.
Patient History Past medical history: none Allergy: none Medication: none Smoking, Alcohol: none Occupation: company employee (single, lives alone) Recent diet: raw vegetables (-) unprocessed water (-) raw meat/fish (-) Sick contact: a coworker, whom he shared a meal with recently, complained of similar symptoms Animal contact: none Travel history: none Exposure to forests, lakes, rivers, oceans: none Review of Systems: (+) fever, chills, lethargy, loss of appetite, headache, diarrhea (–) cough, rhinorrhea, pharyngitis, joint pain
#6.
BT: 39.9°C BP 115/67mmHg HR: 87bpm RR 18/min SpO2 99% (RA) [Conjunctiva] no jaundice, no congestion [Oral cavity] white growth on tongue surface [Neck] no lymphadenopathy, no nuchal rigidity [Paranasal sinuses] no tenderness [Chest] no murmurs, no adventitious sounds [Abdomen] no hepatosplenomegaly, no rebound tenderness, no muscle guarding [Back] no CVA tenderness [Skin] no eruptions [Extremities] no myotonia, no joint pain, no edema [Lymph Nodes] no lymphadenopathy Vital Signs
入院時の胸部X線と検査結果
#7.
Chest X-ray on Admission
#8.
Laboratory Findings
#9.
#1 recurrent fever (2 episodes), vomiting, diarrhea → 1st episode: 49 days prior to admission → 2nd episode 6 days prior to admission 1-1 Recent administration of LVFX 1-2 Coworker complained of similar symptoms #2 Relative bradycardia #3 Mild disturbance in liver function #4 Thrombocytopenia Problem List
鑑別診断と治療計画
#10.
Q1 What is the differential?
#11.
s/o bacterial diarrhea (campylobacter, salmonella, etc.) clostridium-related diarrhea typhoid fever viral gastroenteritis r/o inflammatory bowel disease (Crohn’s disease, ulcerative colitis) thrombotic thrombocytopenic purpura Dengue fever hyperthyroidism infectious mononucleosis, acute retroviral syndrome Differential Diagnoses
#12.
Plan blood culture (2 sets) stool culture, fecal smear in the case of prolonged disease → CT imaging, lower GI endoscopy
血液培養結果とチフス診断
#13.
The following day, 1 out of 2 sets of the blood culture was positive for GNR. The department of infectious diseases was notified. Hospitalization was recommended and treatment was initiated. Clinical Course
#14.
39.5 39 38.5 38 37.5 37 36.5 36 35.5 35 40 1 2 3 ℃ CTRX2g q24h 4 5 6 7 8 9 10 (病日) 139 90 16 88 149 22 8.2 7.8 0.84 0.96 4.16 0.01 4.02 7.51 15.1 26.4 Salmonella typhi was detected from the blood culture Result of the culture (Day 4 of hospitalization)
#15.
Diagnosis: Typhoid (Enteric)Fever
抗菌薬感受性試験の結果
#16.
The organism was not detected in the stool culture. Salmonella typhi Results of the Susceptibility Test
#17.
Zone of inhibition was not seen around the disc of nalidixic acid (right). From the E-test of LVFX, MIC was determined to be 0.5 (left). E-test: Antimicrobial Susceptibility Test
#18.
A: continue CTRX B: switch to MEPM C: switch to LVFX D: switch to AZM (po) E: switch to AZM (iv) Q2 What is the most appropriate course of action?
チフス菌の耐性メカニズム
#19.
40 39.5 39 38.5 38 37.5 37 36.5 36 35.5 35 1 2 3 4 5 6 7 8 9 ℃ CTRX2g q24h 10 Day
#20.
Since the 1990’s, S. typhus that is resistant to nalidixic acid has become increasingly common.Dealing with these strains of S. typhus was clinically challenging even though the MIC of quinolones was determined to be 「S」 for these organisms.In 2013, CLSI (Clinical Laboratory Standard Institute) changed the breakpoint of quinolones with respect to its use against S. typhus. Clinical Laboratory Standards Institute. 2013. Performance standards for antimicrobial susceptibility testing. M100-S23. CLSI, Wayne, PA, USA. チフス菌・パラチフス菌の薬剤感受性に関する3年間の検討 93 日本臨床微生物学雑誌 Vol. 25 No. 2 2015.
#21.
DNA gyrase (gyrA and gyrB) and topoisomerase IV (parC and parE) are the targets of quinolones. Spontaneous point mutations (83rd or 87th positions of the amino acid sequence of gyrA) are thought to induce quinolone resistance. The presence of both point mutations confer a much stronger resistance. ※In recent years, plasmid-mediated quinolone resistance (PMQR) has become increasingly common, in addition to resistance due to point mutations. Mammeri H et al: Emergence of plasmid-mediated quinolone resistance in Escherichia coli in Europe. Antimicrob Agents Chemother 2005; 49: 71-6 The Mechanisms of Quinolone Resistance
食中毒の公表と再発症例
#22.
69 days prior to admission, it is revealed that the patient and his coworker ate a curry dish at a restaurant. The coworker complained of similar symptoms in a similar time course and was also diagnosed with typhoid fever at a different facility.
#23.
Public Announcement from the Tokyo Metropolitan Government: Outbreak of Food Poisoning Caused by Salmonella typhi
#24.
3 weeks after discharge...
再入院時の症状と検査
#25.
The patient complained of a fever of 38℃ with chills, headache, and pharyngeal discomfort. He assumed that his symptoms were due to a cold. However, his condition did not improve; from around the 4th day of the fever, he reported diarrhea that occurred 3-4 times a day. On the 8th day of the fever, he presented to the hospital once again.
#26.
Vital Signs BT: 38.9°C BP 106/57mmHg HR: 66bpm SpO2 98% (RA) RR 20/min [Conjunctiva] no jaundice, congestion [Oral cavity] no abnormalities [Neck] no lymphadenopathy, no nuchal rigidity [Paranasal sinuses] no tenderness [Chest] No murmurs, no adventitious sounds [Abdomen] no hepatosplenomegaly, no rebound tenderness, no muscle guarding [Back] no CVA tenderness [Skin] no eruptions [Extremities] no myotonia, no joint pain, no edema [Lymph Nodes] no lymphadenopathy
#27.
Laboratory Findings
再発の鑑別診断と治療計画
#28.
Q3 What is the differential?
#29.
s/o recurrence of typhoid fever clostridium-related diarrhea bacterial diarrhea (campylobacter, salmonella) viral gastroenteritis r/o inflammatory bowel disease (Crohn’s disease, ulcerative colitis) Legionellosis infectious mononucleosis thrombotic thrombocytopenic purpura hyperthyroidism Differential Diagnoses
#30.
blood test blood culture stool culture (suspected typhoid fever) Clinical Course, Plan 2
再入院時の培養結果と治療方針
#31.
1 2 ℃ 40 39.5 39 38.5 38 37.5 37 36.5 36 35.5 35 3 4 5 6 7 8 9 10 11 12 13 (病日) 45 18 53 37 9.9 12.2 0.7 0.77 1.72 0.08 5.39 4.39 33.1 29.4 CTRX2g q24h Stool culture revealed Salmonella typhi Culture results (day 3 of 2nd hospitalization)
#32.
This time, the organism was not detected in the blood culture. Salmonella typhi Results of the Susceptibility Test
#33.
A: continue CTRX B: switch to MEPM C: switch to LVFX D: switch to AZM (po) E: switch to AZM (iv) Q4 What is the most appropriate course of action?
チフスの疫学とリスク要因
#34.
CTRX2g q24h 1 2 3 4 5 6 7 8 9 10 11 12 ℃ 40 39.5 39 38.5 38 37.5 37 36.5 36 35.5 35 13 (Day)
#35.
A case of typhoid fever that is resistant to nalidixic acid and recurs after CTRX treatment can be successfully treated with AZM. 水野 泰孝ら 感染症学雑誌 86(4), 427-429, 2012 The use of CTRX faces a higher rate of recurrent infection even though no statistically significant difference has been reported between the unresponsiveness of AZM and CTRX (with respect to clinical outcome and antimicrobial activity). Trivedi N A, Shah P C. J Postgrad Med 2012;58:112-8 EUCAST reports the MIC of AZM of S. Typhi: S≦16μg/ml The CLSI reference reports: S≦16μg/ml, R≧32μg/ml 山田浩司ら 日本臨床微生物学雑誌 Vol. 25 No. 2 2015. CLSI. M100-S25. Performance Standards for Antimicrobial. Susceptibility Testing. Although the clinical efficacy of AZM is considerably higher, its access remains a challenge for developing nations due to its higher price. Farmakiotis D, Varughese J, et al. J Travel Med. 2013 Jan-Feb;20(1):17-21. Treatment and Recurrence
#36.
S. typhi and S. paratyphi A are Salmonella enterica serotypes that cause enteric (typhus-related) fever. An infection caused by S. typhi is termed typhoid fever. It is a category III infection in accordance to the Infectious Disease Control in Japan. Epidemiology: It is most commonly seen in Southern/Central Asia and Southern Africa with an incidence of 100 / 100,000 per year. Japan reports around 100 cases per year. S. typhi relies solely on humans carriers for its transmission and spread. Risk Factors: unsanitary conditions, sick contact with typhus carriers. Symptoms: After an incubation period of 5-21 days, patients develop a high fever, myalgia, skin eruptions, cough, hepatosplenomegaly, and abdominal discomfort. Diarrhea appears 2 weeks after the onset of symptoms. Although close observation can be considered as the course of action, it is not without running the risk of GI perforation and hemorrhage. Infections caused by S. typhi have a mortality rate of 10% if left untreat
チフスの診断法と治療法
#37.
Hunter’s Tropical Medicine and Emerging Infectious Diseases. 9th ed. Philadelphia: Saunders; 2013:568-576. Typhoid Fever: Signs, Symptoms
#38.
Diagnostic tests: S. typhi detection rate • blood culture 40-80% • stool culture 30-40% • bone marrow culture 90% Even with a favorable treatment course, the rate of recurrent infection is 5-20%. Treatment: Mandell Douglas and Bennett's Principles and Practice of Infectious Diseases, 8th, Edition
#39.
Cases of Typhoid Fever at Our Institution: (2012-2015)
チフスの慢性キャリアと重要なメッセージ
#40.
IDWR 2013年第39号<注目すべき感染症>腸チフス 2013年 Cases of Typhoid Fever in Japan Reports of Typhoid Fever, Origin of Infection (2000 - 2013) Unknown Unknown Unknown from within Japan n= 136 unknown n= 42 from abroad n= 562 Number of Reports
#41.
3% of untreated patients may become chronic carriers of S. typhus. The organism mainly dwells in the gallbladder where it can remain in the body for over 12 months. It is excreted in the stool of chronic carriers, propagating its dissemination. Chronic carriers may not be significant for typhoid fever in their past medical history. Common comorbidities seen among carriers include biliary tract and urinary tract diseases. S. typhus carriers are also reported to have a highly risk of hepatobiliary cancer compared to the general population. TYPHOID MARY In the wake of the 19th century, Mary Mallon was a cook who infected many of her close contacts with typhoid fever. Further investigation revealed that even an asymptomatic, healthy individual can be a chronic carrier capable of long-term spread of S. typhus. Chronic Carriers
#42.
国立感染症研究所HPより改変 Salmonella Infection
#43.